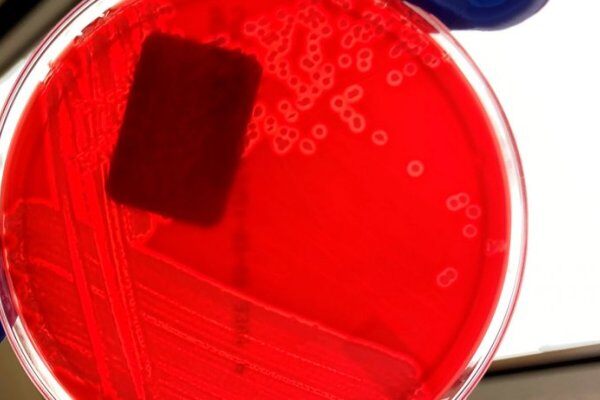
实验室诊断：水肿病

行业资讯
-
不到3天又投20亿!大北农全面发力疫苗、饲料第一目标,迎创业三十周年
近期,大北农和邵根伙频繁“放大招”,引起众多行业人士关注。从宣布打造千亿市值到挑战全球动保十强、猪疫苗登顶国内第一,从与华中农业大学战略合作“5年筹10亿,捐赠1亿”,到分别对厦门大学、贵州大学捐款1亿元,再…
-
温氏股份董监高换届,温志芬当选为董事长,温均生当选为监事会主席,梁志雄连任总裁
12月10日,温氏股份第三次临时股东大会成功召开,温志芬当选董事长,温均生当选监事会主席,梁志雄连任总裁。同时,选举产生了第四届董事会董事及监事会非职工代表监事。 2021年12月10日,温氏股份2021年第三次临时…
-
母猪繁殖场出售苗猪详细操作规程
本着为客户考虑,对公司负责,防止由于车辆运输造成繁殖场污染各种重大传染性疾病,特制定本操作规范:1. 每批猪只 出售或中转方案及售猪生物安全流程必须经过 生产 技术中心审核后由总监签字 方 可执行。2.客户车…
-
祝贺!鹏昌农业副总经理董平天被评为2021年惠州市优秀乡土人才
为进一步加强惠州市乡土人才队伍建设,推进乡村振兴工作,市委人才办联合市农业农村局在全市范围内开展优秀乡土人才遴选培养工作。经县(区)推荐、专家评审及征求相关单位意见,现将遴选结果予以公示。公示期为202…
-
凝聚力量,助力优势瑶鸡育种工作 | 2021川渝地区瑶鸡生产技术研讨会顺利召开
2021年12月10日,由广西鸿光农牧有限公司(以下简称“鸿光农牧”)、广西贵港市港丰农牧有限公司(以下简称“港丰农牧”)、德国勃林格殷格翰(以下简称“勃林格”)、绵阳安旺顺兽药销售有限公司(以下简称“绵阳安旺顺”…
-
地方性流感:亚群与母源抗体之间的平衡
导致动物急性感染的病毒怎么可能一直在猪场中存在?
-
降本增效背景下,瑞奈格微酸性次氯酸消杀为何受亲睐?
近段时间,次氯酸水冰逐渐成为一种新型的非热杀菌保鲜技术。该技术不仅具有普通冰的低温优势, 而且结合了次氯酸水快速、广谱杀灭微生物与较好的保鲜能力的特性, 并且具有作用后的次氯酸水冰可完全还原成无毒、无残…
-
拼搏不止 奋斗不息!第八届中国农牧兄弟联盟男子篮球赛在长沙成功举办
12月9日,第八届中国农牧兄弟联盟男子篮球赛在湖南长沙圆满落幕。7支骁勇战队,4天鏖战,各队球员上下一心、通力合作,经过21场循环赛以及精彩的三分赛和个人技巧赛,为农牧业献出了一届精彩热烈、振奋人心的篮球赛…
-
猪源过剩仍待出清,猪价或难回10元大关
随着腌腊消费旺季的来到,很多人以为猪价能够再度扬帆起航,迎来新的涨停点,但令人意外的是,从12月6日开始,猪价非但没有走高,却迎来了震荡下滑的尴尬局面,并且猪价跌势加码,下跌幅度越来越大。猪价将再度陷入…
-
农业农村部:5年内,超50%规模养殖场实施养殖减抗行动
近期,农业农村部发布《全国兽用抗菌药使用减量化行动方案(2021—2025年)》,提出确保“十四五”时期肉蛋奶等畜禽产品的兽药残留监督抽检合格率稳定保持在98%以上,到2025年末,50%以上的规模养殖场实施养殖减抗行动…
-
创造“芯”价值!正大康地梅州原种猪场获评广东省畜禽养殖标准化示范场
近日,广东省农业农村厅发布了“关于公布 2021 年广东省畜禽养殖标准化示范场名单的通知”,确定了312 家畜禽养殖场为2021 年广东省畜禽养殖标准化示范场。其中,正大康地(梅州)原种猪有限公司正式入选标准化示范场…
-
明年生猪产能暴涨300万头!广垦畜牧亮相广州猪博会,十年深耕亮点逐个看
新猪派记者苏斯铭 时隔两年,养猪产业博览会(广州)将于12月11-13日再度召开,广东广垦畜牧集团股份公司(以下简称广垦畜牧)亦将亮相猪博会。此前,广垦畜牧在猪博会种猪拍卖会上多次取得好成绩,杜洛克和大白分…
-
实验室诊断:水肿病
我可以使用哪些实验室诊断方法来诊断水肿病?我应该根据情况选择哪一种?我如何解释读结果?
-
洪平:从替抗技术到探索适合中国养殖国情的中式配方
新禽况记者 肖鸿秋 2021年12月8日,在湖南长沙铜官窑新华联丽景酒店举办的2021中国动物营养领袖峰会上,安佑集团董事长洪平老师作《从替抗技术到中式配方》主题报告,从替抗技术出发,考虑到动物健康养殖以及到中式…
-
禾丰牧业高全利:新格局下的饲料企业成长与发展之道 | 2021中国动物营养领袖峰会
新猪派记者陈淑梅 12月8日上午,在湖南长沙举办的2021中国动物营养领袖峰会上,禾丰牧业股份有限公司常务副总裁高全利作《新融合:饲料与养殖的融合与赋能》主题报告,讲述了新格局下饲料企业成长与发展之道。2021…
-
农业农村部:5年内80%国家畜禽核心育种场通过动物疫病净化评估
农业农村部:5年内80%国家畜禽核心育种场通过动物疫病净化评估 日 前,农业农村部发布《关于推进动物疫病净化工作的意见》,提出了以种畜 禽场为核心,通过示范创建、引导支持,以点带面、逐步推开的方式,目标在五…
-
落后产能淘汰进行时,二元母猪占比已超94%!
2021年生猪产能释放,能繁母猪存栏量触顶回调,出栏量“阶梯式”增长,规模养殖场率先对种群结构进行优化和调整,母猪群体结构中二元比例逐步提升,落后产能正在淘汰进行时。上游能繁母猪及生猪存栏量有何变化,以及…
-
母猪诱导分娩对产活仔数的影响
题目:了解诱导分娩对产活仔数的影响简介:诱导分娩可以使分娩同步化,增加了工作人员监督分娩的时间,提高生产的效率。与自然分娩相比,加强分娩监督会使每窝仔猪死胎数减少。理论上妊娠期每增加一天,仔猪平均生…
-
星光闪耀!200多位饲料大咖齐聚2021中国动物营养领袖峰会
星光闪耀!200多位饲料大咖齐聚2021中国动物营养领袖峰会 新猪派 汤欢欢湘江边上,群英荟萃,挥斥方遒!12月7-8日,由长沙兴嘉生物工程股份有限公司主办,新猪派&新禽况策划的2021中国动物营养领袖峰会在长沙隆…
-
勃林格殷格翰任命刘静娴为大中华区动物保健业务负责人
12月8日,动物保健领域全球领导企业勃林格殷格翰宣布,刘静娴女士将于2022年1月1日加入勃林格殷格翰,担任该公司大中华区动物保健业务负责人一职。刘静娴将向勃林格殷格翰全球高级副总裁、大中华区总裁兼CEO高齐飞…
.png)